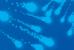

• AddLoad Funktion zum Nachlegen von vergessenen Wäschestücken • Bügeln leicht gemacht dank Vorbügeln • ProfiEco Motor – sparsam, langlebig und leise • Laugenbehälter aus Edelstahl und Kontergewichte aus Grauguss • Startvorwahl und Restzeitanzeige



































































































































































Markenqualität zu Superpreisen









































Gültig vom 27.12. bis 31.12.2022 www.kundenspiegel.de MF Consulting Dipl.-Kfm. Dieter Grett 7.SAARBRÜCKER KUNDENSPIEGEL Untersucht:6Elektro-/Elektronikgeschäfte 91,0%DurchschnittlicherZufriedenheitsgrad Freundlichkeit:96,6%(Platz1) Beratungsqualität:94,6%(Platz1) Preis-Leistungs-Verhältnis:81,9%(Platz1) Kundenbefragung:10/2020 Befragte(Elektro)=796vonN(Gesamt)=912 * *untersucht wurden Saarbrücken und Altenkessel-Rockershausen TYPISCH POWER-LEISTUNG FÜR UNSERE KUNDEN: Auf 15.000 m2 Gesamtbetriebsfläche, davon 7.000 m2 bebaute Fläche, wollen unsere freundlichen und qualifizierten Mitarbeiter, dass Sie zufrieden sind. über 200 Mitarbeiter in 3 Häusern Unsere eigene Meisterwerkstatt bietet mit über 35 Servicefahrzeugen und über 50 Servicekräften auch perfekte Betreuung im Servicefall.
Bei uns erwartet Sie fachmännische Beratung durch bestens geschultes Personal in allen Abteilungen unserer Häuser. Unsere Mitarbeiter werden ständig weitergebildet, um Ihnen stets mit Rat und Tat zur Seite zu stehen! Geschultes Personal TOP-Preise durch
Kundendienst
zentralen Einkauf. Markenqualität vieler namhafter Hersteller. 14 Tage Preisgarantie.
während der Laufzeit.
ab 200,-€ bis zu 24 Monate Laufzeit 0% Effektiv-Jahreszins. TOP-Ratenzahlung ohne Bank BERATUNG, SERVICE großgeschrieben ... ... und trotzdem günstige Preise! • Wir erstatten Ihnen
14
Artikel
bespielter Bild-
gleicher
Region billiger
PREISGARANTIE BEWÄHRT SEIT 45 JAHREN Niedrige Monatsraten 54 Monate Laufzeit 3 Monatsraten Kaution zu zahlen bei Vertragsbeginn Komplette Abwicklung im eigenen Haus Alle Reparatur- und Wartungskosten während der gesamten Laufzeit im Preis enthalten Kein zusätzlicher Service-Vertrag erforderlich Ersatzgerät bei längerer Reparaturzeit Telefonische Bestellung unter: 0 68 06/600 60 Faxbestellung oder Reservierung unter: 0 68 06/60 06 36 IHR VORTEIL LEASING-SYSTEM Wir wünschen Ihnen ein gesundes und glückliches Jahr 2023! 1962-2022 Wir wollen, dass Sie zufrieden sind! FACHGESCHÄFT 1400 Schleudertouren Wasch-Trocken-Säule Tower 200 Bestell-Nr.: 353 028 bestehend aus: Wärmepumpentrockner TWD 449 WP • 1 - 8 kg Fassungsvermögen durch DirectSensor Bedienung • Spezielle Trocknungsprogramme wie Jeans, Express, Lüften warm, Vorbügeln, Oberhemden und FinishWolle • Startzeitvorwahl und Restzeitanzeige • Intelligente Trommelreversierung inkl. Miele Zwischenbausatz WTV 502 Geräte nicht einzeln erhältlich! Waschvollautomat WWD 129 WPS • 1 - 8 kg Fassungsvermögen • 600 - 1400 U/Min. Schleudertouren • Spezialprogramme wie: Express 20, Oberhemden, Dunkles/Jeans, Eco 40 - 60 und Imprägnieren
Sparsam, schonend und komfortabel Geräte übereinander oder getrennt aufstellbar Liefer-Barpreis 1929.EnergieEffizienzKlasse A+++ Spektrum: A+++ bis D mtl. SUPER54 MONATE LEASINGVORTEILE INKL. REPARATUR + WARTUNG Vertragsentgelt 54 Monate x 39,50 € mtl. Leasinggebühr = 2133,00 € (3 Monatsraten Kaution zu zahlen bei Vertragsbeginn) LEASING 39.50 SuperLeasingknüller
Bewährt seit 45 Jahren, 54 Monate Leasingvorteile inkl. Reparatur und Wartung und 3 Monatsraten Kaution. Niedrige Monatsraten und keine Kostensteigerung durch Lohn-, Steuererhöhungen oder Anstieg der Materialkosten
Super-Leasing
den Differenzbetrag, wenn Sie innerhalb von
Tagen nach dem Kauf nachweisen, dass Sie den gekauften
(mit Ausnahme
und Tonträger) bei
Leistung in unserer
kaufen können.




















































































































































































































































































KUNDENDIENST 0 68 06/60 06 49 1962 - 2022 über 3000 Fachgeschäfte in Europa Pyrolyse – umweltfreundlich, hygienisch und komfortabel EnergieEffizienzKlasse Spektrum: A+++ bis D A Mit 10 Automatik-Programmen wird Kochen zum Kinder-spiel. Einfach das Gargut einlegen, passendes Gericht und Gewicht wählen und das Programm starten Einbau-Backofen CF 6 M 77050 • Einbau-Backofen mit 7 Beheizungsarten • 3D-Heißluft, Ober-/Unterhitze, Umluftgrill, Pizzastufe, separat schaltbare Unterhitze, Heißluft sanft, Vario-Großflächengrill • Pyrolytische Selbstreinigung • Schnellaufheizung: bis zu 30%
Vorheiz-Zeiten • Elektronikuhr mit Tageszeitanzeige •
versenkbar •
• 1 x
1 x Pizzaform, 1 x Universalpfanne •
H 59,5 x B 59,4 x T 54,8 cm Bestell-Nr.: 370 711 Wärmepumpentrockner T 9 DE 860 EX Bestell-Nr.: 411 834 • Fassungsvermögen 1 - 8 kg • Programme: Bettwäsche XL, Baumwolle ECO, Baumwolle, Feinwäsche, Hygiene, MixDry, Outdoor, Seide, Pflegeleicht, Wolle • ProSense®-Mengenautomatik, spart Zeit und Energie • Verlängerter Knitterschutz • AbsoluteCare® System mit Woolmark Blue Zertifikat • ProTex Schontrommel • Anzeigen für Sieb, Behälter, Wärmetauscher • Reversierautomatik • Extra große Einfüllöffnung, Türanschlag rechts, wechselbar • Leise Option reduziert das Betriebsgeräusch • Mitgeliefertes Zubehör: Ablaufschlauch für Kondenswasser (240 cm) mtl. 19.SUPER54 MONATE LEASINGVORTEILE INKL. REPARATUR + WARTUNG Vertragsentgelt 54 Monate x 19,00 € mtl. Leasinggebühr = 1026,00 € (3 Monatsraten Kaution zu zahlen bei Vertragsbeginn) LEASING SuperLeasingknüller mtl. 14.SUPER54 MONATE LEASINGVORTEILE INKL. REPARATUR + WARTUNG Vertragsentgelt 54 Monate x 14,00 € mtl. Leasinggebühr = 756,00 € (3 Monatsraten Kaution zu zahlen bei Vertragsbeginn) LEASING Vollintegrierbarer Geschirrspüler SMV 6 ZCX 09 E Bestell-Nr. 380 541 • MaxFlex Pro Korbsystem • Farbige Anti-Rutsch-Beschichtung im Oberkorb • 6 Programme: Eco 50 °C, Auto 45-65 °C, Intensiv 70 °C, 1,5h 60 °C, Silence 50 °C, Favorit • 4 Sonderfunktionen: Fernstart, Extra Trocknen, HalbeBeladung, SpeedPerfect+ • Startzeitvorwahl: 1-24 Stunden • Home Connect-fähig über WLAN • Geeignet für Küchenfronten von 65,5 bis 72,5 cm Länge Wir für SIE –alles aus einer Hand! zentraler & Meister-Werkstätten Kundendienst günstige Pauschalpreise betriebsbereiter Übergabe Anschluss- Service mit große in allen Warengruppen Auswahl Kostenlose vor Ort Parkplätze P kompetente Fachberatung großes in Heusweiler Zentral-Lager kostenfreier bei Mitnahme AnhängerVerleih LieferMontage-Teams eigene und hausinternes Leasing- & Finanzierungssystem bei längerer Reparatur-Wartezeit Leihgerät Altgeräte& Verpackungs-Entsorgung Umweltgerechte Selbstabholen wird belohnt! Bei Abholung Ihres Großgerätes in einem unserer Lager erhalten Sie eine Vergütung von 25,- € auf den Liefer-Barpreis. Bei Abholung und Selbstmontage eines Einbau-Großgerätes erhalten Sie eine Vergütung von 59,- € auf den Liefer-Barpreis. PerfectDry mit Zeolith®-Technologie: perfekte Trocknungsergebnisse mit weniger Energieverbrauch Extra Clean Zone: extra gründliche Reinigung für stark verschmutztes Geschirr im Oberkorb Liefer-Barpreis 999.Liefer-Barpreis 669.Liefer-Barpreis 928.Liefer-Barpreis 599.ohne Inhalt EnergieEffizienzKlasse A+++ Spektrum: A+++ bis D Neues Modell mtl. 20.SUPER54 MONATE LEASINGVORTEILE INKL. REPARATUR + WARTUNG Vertragsentgelt 54 Monate x 20,00 € mtl. Leasinggebühr = 1080,00 € (3 Monatsraten Kaution zu zahlen bei Vertragsbeginn) LEASING SuperLeasingknüller Das MixDry Programm: Trocknet Ihre Kleidungsstücke aus Synthetik und Baumwolle sorgfältig, gleichmäßig und mit der exakt richtigen Temperatur AbsoluteCare®: Garantiert kein Einlaufen - selbst bei empfindlichen Stücken 1400 Schleudertouren mtl. SUPER54 MONATE LEASINGVORTEILE INKL. REPARATUR + WARTUNG Vertragsentgelt 54 Monate x 15,50 € mtl. Leasinggebühr = 837,00 € (3 Monatsraten Kaution zu zahlen bei Vertragsbeginn) LEASING 15.50 SuperLeasingknüller Sonderposten begrenzte Stückzahl Abgabe nur in haushaltsüblichen Mengen MyMix Programm: Gründliche, energiesparende Reinigung in nur 69 Minuten Anti-Allergie: Entfernt über 99,99% der Keime und Bakterien Waschmaschine L 7 FBG 61480 Bestell-Nr.: 396 023 • 1 - 8 kg Fassungsvermögen • 400 - 1400 U/min. Schleudertouren • ProTex Öko-Schontrommel • Programme: Eco 40-60, Baumwolle, Pflegeleicht, MyMix 69min, Feinwäsche, Schleudern/Pumpen, Anti-Allergie mit Dampf • Universale Fleckenoption • Integrierte Flüssigwaschmitteleinspülung • Nachlegefunktion & Restzeitanzeige • ProSense® Mengenautomatik: Spart Wasser, Energie und Zeit
kürzere
Drehknebel,
Teleskopauszug nachrüstbar
Kombirost,
Maße:











































































































































































































































































































































































KUNDENDIENST 0 68 06/60 06 49 1962 - 2022 Wir wollen, dass Sie zufrieden sind! HEUSWEILER • SAARBRÜCKEN ALTENKESSEL-ROCKERSHAUSEN Sonderposten begrenzte Stückzahl Abgabe nur in haushaltsüblichen Mengen Saugroboter Roomba i3+ • Dirt Detect™-Sensoren erkennen besonders verschmutzte Stellen • Anti-Allergen-Beutel sammeln und verschließen 99 % an Pollen und Schimmel • Ecken- und Kantenreinigungsbürste Bestell-Nr.: 381 152 Heizkissen Limited Edition 2022 Sonderposten begrenzte Stückzahl Abgabe nur in haushaltsüblichen Mengen Inkl. Stand-Ladestation, Turbo-Bürste, Soft-Bürste, Mini-Turbo-Bürste, Flex-Adapter und Kombi-Fugendüse * Für die Reinigungsstufe „Wet“ wird der Wischaufsatz benötigt. Der Spinning Sweeper Wischaufsatz ist nicht im Lieferumfang inkludiert und separat erhältlich. Sollzinssatz (jährl. und gebunden für die Laufzeit) und effektiver Jahreszins betragen 0%. Laufzeit 24 Monate. Der Barzahlungspreis entspricht dem Nettodarlehensbetrag. Bonität vorausgesetzt. F 0% Zinsen F Ab 200,- € bis zu 24 Monate Laufzeit! Ohne Bank und ohne Bearbeitungsgebühr F Akku-Handstaubsauger Jet 90 Complete Extra VS20R9076T7/EG • Wechselbarer 21,9 V Akku • Laufzeit pro Akku: bis zu 60 Minuten • Ladezeit: 3,5 Stunden • Saugrohr in 4 verschiedenen Stufen einstellbar • 4 Reinigungsstufen (Min/Mid/Max/Wet*) • Staubbehälter und Multi-Cyclone Systems komplett auswaschbar Bestell-Nr.: 383 935 • 1,9 Liter Wassertank • 280 Gramm Bohnenbehälter mit Aromaschutzdeckel • 8 Kaffeestärken individuell einstell- & programmierbar • Latte Macchiato, Cappuccino uvm. auf Knopfdruck • One-Touch-Milchsystem-Reinigung • Professional Aroma Grinder-Mahlwerk • Künstliche Intelligenz: Passt das Display auf Ihre Lieblingsprodukte an Extra Shot: für intensiveren Geschmack mtl. 23.SUPER54 MONATE LEASINGVORTEILE INKL. REPARATUR + WARTUNG Vertragsentgelt 54 Monate x 23,00 € mtl. Leasinggebühr = 1242,00 € (3 Monatsraten Kaution zu zahlen bei Vertragsbeginn) BIS ZU 15.000 TASSENBEZÜGE LEASING Kaffeevollautomat E 8 Chrom 15363 Bestell-Nr.: 369 584 Gerät ohne Deko Autorisierter KaffeevollautomatenService für ... Abhol-Barpreis 699.mtl. 16.SUPER54 MONATE LEASINGVORTEILE INKL. REPARATUR + WARTUNG Vertragsentgelt 54 Monate x 16,00 € mtl. Leasinggebühr = 864,00 € (3 Monatsraten Kaution zu zahlen bei Vertragsbeginn) LEASING Abhol-Barpreis 1069.Kaffeepadmaschine Senseo HD7865/60 QUADRANTE • Die Senseo Kaffee Boost Technologie holt das Beste aus Ihrem Pad heraus • Seitlicher, leicht abnehmbarer Wasserbehälter • Anpassbare Abtropfschale für Ihre Lieblingstasse • Automatische Endabschaltung nach 30 Minuten Bestell-Nr.: 231 633 • Flauschig weiches Heizkissen • Atmungsaktiv, anschmiegsam und hautsympathisch • Maschinenwäsche bis 30 °C • Elektronische Temperaturregelung • Abschaltautomatik nach ca. 90 Minuten • Produktmaße: L 44 x B 33 cm Bestell-Nr.: 411 244 Gerät ohne Deko Kann 2 Tassen gleichzeitig zubereiten Steuerung und Planung der Reinigung per App und Sprachsteuerung Clean Base® – Autom. Absaugstation Jetzt auch im Leasing Smartphone ist nicht im LIeferumfang enthalten ANGEBOT DER WOCHE F mit 24 Monaten Elektro R. Meyer Garantie 299.Abhol-Barpreis 0% Ratenzahlung: 24 x 12,45 € monatlich = 299,- € 590 mm 520 mm EnergieEffizienzKlasse A Spektrum: A+++ bis D Einbau-Herd: • 1-fach Teleskopvollauszug • Versenkbare Knebel • Ober-/Unterhitze, Heißluft, Umluftgrill, Grill, Kleinflächengrill, Pizzastufe • Uhr mit Timer-Funktion Ceran-Kochfeld: • Glaskeramik-Kochfläche von SCHOTT CERAN® • Edelstahlrahmen • Zweikreis- und Bräterzone • Restwärmeanzeige • Ausschnitt: 560 x 490 mm Bestell-Nr.: 342 683 Einbau-Herdset F-NB 69 R 2301 RS 3-StufenReinigungssystem: 2 Gummibürsten lösen festsitzenden Schmutz Preishit 32.Abhol-Barpreis • 2,2 Liter Wassertank • 250 Gramm Bohnenbehälter • 5 Kaffeestärken einstellbar • MEIN KAFFEE: 5 Kaffeerezepte individuell einstellen und speichern • Cappuccino, Latte Macchiato auf Knopfdruck • Bluetooth fähig: bequeme Bedienung via Nivona App Bestell-Nr.: 393 732 Kaffeevollautomat CafeRomatica NICR 795 Gerät ohne Deko mtl. 19.SUPER54 MONATE LEASINGVORTEILE INKL. REPARATUR + WARTUNG Vertragsentgelt 54 Monate x 19,00 € mtl. Leasinggebühr = 1026,00 € (3 Monatsraten Kaution zu zahlen bei Vertragsbeginn) BIS ZU 15.000 TASSENBEZÜGE LEASING Abhol-Barpreis 849.3 Aromaprofile für ein Maximum an Aroma F mit 24 Monaten Elektro R. Meyer Garantie 540.0% Ratenzahlung: 24 x 22,50 € monatlich = 540,- € Abhol-Barpreis 99.Abhol-Barpreis
Wir erstatten Ihnen den Differenzbetrag, wenn Sie innerhalb von 14 Tagen nach dem Kauf nachweisen, dass Sie den gekauften Artikel (mit Ausnahme bespielter

und Tonträger) bei gleicher Leistung in unserer Region billiger kaufen können.




































1962 - 2022 über 3000 Fachgeschäfte in Europa Unsere aktuellen Angebote abrufbereit im Internet: www.elektromeyer.de 108cm Bildschirmdiagonale QLED HD-DVB-T2, HD-Kabel und HD-Sat Sonderposten begrenzte Stückzahl Abgabe nur in haushaltsüblichen Mengen Thema: •
Bild-
PREISGARANTIE QLED-TV GQ 43 LS 03 B • 108 cm Bildschirmdiagonale • Auflösung: 3840 x 2160 Pixel • 3100 PQI (Picture Quality Index), • One Connect Box, One Cable Solution • WLAN integriert, Smart-TV • 4 x HDMI, 2 x USB, CI+, Bluetooth • B 96,9 x H 59,2 x T 2,5 cm Bestell-Nr.: 404 626 mtl. 16.SUPER54 MONATE LEASINGVORTEILE INKL. REPARATUR + WARTUNG Vertragsentgelt 54 Monate x 16,00 € mtl. Leasinggebühr = 864,00 € (3 Monatsraten Kaution zu zahlen bei Vertragsbeginn) LEASING Preishit F mit 24 Monaten Elektro R. Meyer Garantie 699.-Abhol-Barpreis 0% Ratenzahlung: 24 x 29,12 € monatlich = 699,- € Folgen Sie uns unter @elektromeyer.saar auf Facebook und Instagram Die Kunst des Fernsehens: The Frame Einzigartiges Design – The Frame TV ergänzt Ihre Inneneinrichtung und spiegelt Ihren Stil mithilfe einer Auswahl eleganter Bilderrahmen. Individualisieren Sie Ihren The Frame TV mit einer variierbaren Auswahl an Designelementen und Bildinhalten. HD-DVB-T2, HD-Kabel und HD-Sat USB-Aufnahme Android-TV 139cm Bildschirmdiagonale LED Ultra-HD HDR mtl. SUPER54 MONATE LEASINGVORTEILE INKL. REPARATUR + WARTUNG Vertragsentgelt 54 Monate x 22,50 € mtl. Leasinggebühr = 1215,00 € (3 Monatsraten Kaution zu zahlen bei Vertragsbeginn) LEASING 22.50 SuperLeasingknüller LED-TV TX 55 LXX 889 • 139 Bildschirmdiagonale • Auflösung: 3840 x 2160 Pixel Ultra-HD (4K) • Android-TV mit Zugriff auf viele Apps • WLAN integriert, Smart-TV • 3 x HDMI, 2 x USB, Bluetooth • B 123,4 x H 76,8 x T 8,3 cm Bestell-Nr.: 410 339 Liefer-Barpreis 1099.Sollzinssatz (jährl. und gebunden für die Laufzeit) und effektiver Jahreszins betragen 0%. Laufzeit 24 Monate. Der Barzahlungspreis entspricht dem Nettodarlehensbetrag. Bonität vorausgesetzt. F 0% Zinsen F Ab 200,- € bis zu 24 Monate Laufzeit! Ohne Bank und ohne Bearbeitungsgebühr F Rechenbeispiel: TV TX 55 LXX 889: Aktions-Abzug TV: Liefer-Barpreis: 1199.1099.-100.Cashback -Aktionswochen vom 01.10.2022 - 08.01.2023 Sonderposten begrenzte Stückzahl Abgabe nur in haushaltsüblichen Mengen


























































































































































































0 68 06/60 06 49 1962 - 2022 Wir wollen, dass Sie zufrieden sind! HEUSWEILER • SAARBRÜCKEN ALTENKESSEL-ROCKERSHAUSEN Liefer-Barpreis 1699.OLED-TV XR 55 A 90 • 139 cm Bildschirmdiagonale • Auflösung: 3840 x 2160 Pixel Ultra-HD (4K) • Cognitive Processor XR, Dolby Vision, IMAX Enhanced • WLAN integriert, Smart-TV • 4 x HDMI, 2 x USB, Bluetooth • B 128,2 x H 77,6 x T 7,3 cm Bestell-Nr.: 382 086 mtl. 34.SUPER54 MONATE LEASINGVORTEILE INKL. REPARATUR + WARTUNG Vertragsentgelt 54 Monate x 34,00 € mtl. Leasinggebühr = 1836,00 € (3 Monatsraten Kaution zu zahlen bei Vertragsbeginn) LEASING SuperLeasingknüller 139cm Bildschirmdiagonale OLED Streaming Service BRAVIA Core™ integriert 2 x HD-DVB-T2, 2 x HD-Kabel und 2 x HD-Sat Sonderposten begrenzte Stückzahl Abgabe nur in haushaltsüblichen Mengen 4-seitiges Ambilight! HD-DVB-T2, HD-Kabel und HD-Sat HDR10+ 165cm Bildschirmdiagonale OLED Mit dem 4-seitigem Ambilight von Philips fühlt sich jeder Moment echt an. Intelligente LEDs, die den Fernseher umranden, reagieren auf die Handlungen auf dem Bildschirm. 70 Watt Liefer-Barpreis 1999.Dank kognitiver Intelligenz versteht dieser BRAVIA XR Fernseher wie Menschen sehen und hören, somit sorgt er für ein revolutionäres TV-Erlebnis. LEASING Thema: IHR VORTEILVolle Kostenkontrolle und Sicherheit Keine Kostensteigerung der Leasingraten während der gesamten 54 monatlichen Laufzeit durch Lohn- und Steuererhöhungen oder steigende Materialkosten. Keine versteckte Kosten, da alle Reparatur- und Wartungskosten während der gesamten Laufzeit im Preis enthalten sind. 3 Monatsraten Kaution, zahlbar bei Vertragsbeginn. Ersatzgerät bei längerer Reparaturzeit. Komplette Abwicklung im eigenen Haus. OLED-TV 65 OLED 936 • 165 cm Bildschirmdigonale • Auflösung: 3840 x 2160 Pixel Ultra-HD (4K) • P5 Dual Picture Engine mit KI, HDR10+ • Dolby Vision und Dolby Atmos • WLAN integriert, Smart-TV • 4 x HDMI, 3 x USB, CI+, Bluetooth • B 144,9 x H 93,1 x T 4,73 cm • Auslaufmodell Bestell-Nr.: 396 554 mtl. 40.SUPER54 MONATE LEASINGVORTEILE INKL. REPARATUR + WARTUNG Vertragsentgelt 54 Monate x 40,00 € mtl. Leasinggebühr = 2160,00 € (3 Monatsraten Kaution zu zahlen bei Vertragsbeginn) LEASING SuperLeasingknüller Restposten begrenzte Stückzahl Auslaufmodell









































































































































































































KUNDENDIENST 0 68 06/60 06 49 über 3000 Fachgeschäfte in Europa DIE NEUE DIMENSION DER REALITÄT SEIT 45 JAHREN LEASING - IHR VORTEIL! 1962 - 2022 RIESIGESBILD 217cm Liefer-Barpreis 2599.LED-TV 86 PUS 8807 • 217 cm Bildschirmdiagonale • Auflösung: 3840 x 2160 Pixel Ultra-HD (4K) • HDR, HDR10, HLG, HDR10+, Dolby Vision • WLAN integriert, Android Smart-TV • 4 x HDMI, 2 x USB, Bluetooth • B 193,1 x H 117,3 x T 10,3 cm Bestell-Nr.: 412 660 217cm Bildschirmdiagonale LED Ultra-HD HD-DVB-T2, HD-Kabel und HD-Sat 3-seitiges Ambilight! mtl. 52.SUPER54 MONATE LEASINGVORTEILE INKL. REPARATUR + WARTUNG Vertragsentgelt 54 Monate x 52,00 € mtl. Leasinggebühr = 2808,00 € (3 Monatsraten Kaution zu zahlen bei Vertragsbeginn) LEASING SuperLeasingknüller Sonderposten begrenzte Stückzahl Abgabe nur in haushaltsüblichen Mengen MIT NEO QLED 8K 189cm Bildschirmdiagonale QLED Ultra-HD (8K) Neural Quantum Prozessor 8K Gaming in 120-Hz-Qualität 2 x HD-DVB-T2, 2 x HD-Kabel und 2 x HD-Sat mtl. 64.SUPER54 MONATE LEASINGVORTEILE INKL. REPARATUR + WARTUNG Vertragsentgelt 54 Monate x 64,00 € mtl. Leasinggebühr = 3456,00 € (3 Monatsraten Kaution zu zahlen bei Vertragsbeginn) LEASING SuperLeasingknüller 189cm GROSSESBILD Liefer-Barpreis 3199.QLED-TV GQ 75 QN 800 BTXZG • 189 cm Bildschirmdiagonale • Auflösung: 7.680 x 4.320 Pixel Ultra-HD (8K) • HDR 10+, USB-Aufnahme • WLAN integriert, Smart-TV • 4 x HDMI, 3 x USB, Bluetooth • B 166,8 x H 102,3 x T 1,7 cm Bestell-Nr.: 404 662 Sonderposten begrenzte Stückzahl Abgabe nur in haushaltsüblichen Mengen
















































































































































































































































































































1962 - 2022 Wir wollen, dass Sie zufrieden sind! HEUSWEILER • SAARBRÜCKEN ALTENKESSEL-ROCKERSHAUSEN
•
Thema:
Wir erstatten Ihnen den Differenzbetrag, wenn Sie innerhalb von 14 Tagen nach dem Kauf nachweisen, dass Sie den gekauften Artikel (mit Ausnahme bespielter Bild- und Tonträger) bei gleicher Leistung in unserer Region billiger kaufen können.
Tragbarer wasserdichter Lautsprecher Sonderposten begrenzte Stückzahl Abgabe nur in haushaltsüblichen Mengen Bluetooth-Lautsprecher Flip 6 • 2-Wege-Lautsprechersystem, das so konstruiert wurde, dass es einen lauten, kristallklaren, kraftvollen Sound liefert • Kabelloses Streamen via Bluetooth • Bis zu 12 Stunden Wiedergabezeit • IP67 wasserdicht und staubfest Bestell-Nr.: 396
blau 396
rot 402
schwarz Sollzinssatz (jährl. und gebunden für die Laufzeit) und effektiver Jahreszins betragen 0%. Laufzeit 24 Monate. Der Barzahlungspreis entspricht dem Nettodarlehensbetrag. Bonität vorausgesetzt. F 129.Abhol-Barpreis 0% Zinsen F Ab 200,- € bis zu 24 Monate Laufzeit! Ohne Bank und ohne Bearbeitungsgebühr F Stereoanlage MCR-B 370 D Silber • 2 x 20 Watt Ausgangsleistung • Digitalradio mit DAB+ bietet eine große Auswahl an Radiostationen mit Klang in höchster Qualität • Wiedergabe von CD, CD-R/RW und MP3 • Bluetooth und USB-Eingang Bestell-Nr.: 323 576 F mit 24 Monaten Elektro R. Meyer Garantie 349.-Abhol-Barpreis 0% Ratenzahlung: 24 x 14,54 € monatlich = 349,- € Internetradio Digitradio 650 • 2.1 Soundsystem mit 70 Watt Ausgangsleistung • DAB+ und Internetradio • Wireless Charging – zum Aufladen von Smartphones • Audiostreaming (Bluetooth, Spotify) • CD-Player mit MP3-Wiedergabe • B 50 x H 18 x T 27 cm Bestell-Nr.: 397 192 Beim DIGITRADIO 650 wurde erneut mit den deutschen Soundexperten von ELAC zusammengearbeitet, um die bestmögliche Klangabstimmung aus dem 2.1-System heraus zu kitzeln. Über den Equalizer nehmen Sie das individuelle Klangfeintuning vor. 0% Ratenzahlung: 24 x 26,20 € monatlich = 629,-€ F mit 24 Monaten Elektro R. Meyer Garantie 629.Abhol-Barpreis Soundbar HW-Q 810 B • Ausgangsleistung: 360 Watt • 5.1.2 Kanal mit 11 integrierten Lautsprechern • Bild und Klang perfekt auf Ihr Raum abgestimmt –SpaceFit Sound 2 • Packendes Surround Sound-Erlebnis dank kabelloser Dolby Atmos- und DTS:X-Unterstützung • 2 x HDMI, Bluetooth, AirPlay 2 Bestell-Nr.: 404 905 Abhol-Barpreis 560.mtl. 13.SUPER54 MONATE LEASINGVORTEILE INKL. REPARATUR + WARTUNG Vertragsentgelt 54 Monate x 13,00 € mtl. Leasinggebühr = 702,00 € (3 Monatsraten Kaution zu zahlen bei Vertragsbeginn) LEASING mtl. 18.SUPER54 MONATE LEASINGVORTEILE INKL. REPARATUR + WARTUNG Vertragsentgelt 54 Monate x 18,00 € mtl. Leasinggebühr = 972,00 € (3 Monatsraten Kaution zu zahlen bei Vertragsbeginn) LEASING SuperLeasingknüller Smartradio Passion • Triple-Radio: Internet Radio, DAB+, UKW • CD-Player, WLAN, Bluetooth Wireless Streaming • Integrierte Lautsprecher, Wireless charging • Wecker- und Schlummerfunktion • 4 Schnellspeichertasten Bestell-Nr.: 410 036 Dimmbares Display DAB+ Radio für den digitalen Empfang von z.B. Deutschlandfunk Kräftiger Sound und viele Features! Abhol-Barpreis 899.-
PREISGARANTIE
703
707
348


































































































































































































































































































































































Irrtümer und Preisänderungen, sowie technische Änderungen der Geräte vorbehalten. FACHGESCHÄFT FÜR SIE GEÖFFNET: In Heusweiler, Saarbrücken und Altenkessel-Rockershausen Samstag 9.00 - 18.00 Mo. - Fr. 9.00 - 19.00 ZENTRALER KUNDENDIENST: 06806/600649 INTERNET: http://www.elektromeyer.de 66265 HEUSWEILER (Hauptsitz) Holzer Straße 54 06806/60060 info@elektromeyer.de 66113 SAARBRÜCKEN (Filiale) Friedr.-Hecker-Str. 1-5 0681/991920 saarbruecken@elektromeyer.de 66126 ALTENKESSEL-ROCKERSHAUSEN (Filiale) Provinzialstraße 75 06898/98620 altenkessel@elektromeyer.de Elektro R. Meyer GmbH & Co. KG T T T @ @ @ P Kostenlose Parkplätze am Haus 1962 - 2022 Sollzinssatz (jährl. und gebunden für die Laufzeit) und effektiver Jahreszins betragen 0%. Laufzeit 24 Monate. Der Barzahlungspreis entspricht dem Nettodarlehensbetrag. Bonität vorausgesetzt. F SEIT 45 JAHREN DER LEASING SPEZIALIST Notebook A317-53-55SR Bestell-Nr.: 408 012 • 512 GB SSD-Laufwerk • Intel® Iris® Xe Grafikkarte • LAN, WLAN ac, Bluetooth 4.0, HDMI • 2 x USB 3.2, 1 x USB 2.0 • Integrierte WebCam, integrierter Nummernblock • Microsoft® Windows® 11 64 Bit • Intel® Core™ i5-1135G7 Prozessor der elften Generation (bis zu 4,20 GHz mit Intel® TurboBoost-Technik 2.0, 8 MB Intel® Smart-Cache) • 44 cm (17,3”) Full HD IPS Acer ComfyView™ Display mit LED-Hintergrundbeleuchtung, 1920 x 1080, 16 : 9 • 12 GB Arbeitsspeicher 40,64cm (16‘‘) AMD Ryzen™ 5 5600H Prozessor 16 GB Arbeitsspeicher 512 GB SSD-Laufwerk • AMD Ryzen™ 5 5600H Prozessor (bis zu 4,20 GHz, 16 MB Cache) • 40,64 cm (16”) entspiegeltes WQXGA IPS Display mit LEDHintergrundbeleuchtung, 2560 x 1600, 16 : 9 • 16 GB Arbeitsspeicher Notebook IdeaPad 5 Pro 16ACH6 Bestell-Nr.: 411 660 • 512 GB SSD-Laufwerk • AMD Radeon™ Grafikkarte • WLAN ax, Bluetooth 5.1, HDMI • 2 x USB 3.2, 1 x USB 3.2 Type-C • Integrierte WebCam, beleuchtete Tastatur • Microsoft® Windows® 11 64 Bit Abhol-Barpreis 699.Abhol-Barpreis 799.Smartphone moto g22 4 GB + 64 GB • 16,51 cm (6,5“) HD+ Display • 2,3 GHz Octa-Core Prozessor • 4 GB Arbeitsspeicher, 64 GB interner Speicher, erweiterbar durch microSD-Card (bis zu 1 TB) • Quad-Hauptkamera (50 Megapixel + 8 Megapixel + 2 Megapixel + 2 Megapixel), 16 Megapixel Frontkamera • WiFi 5, Bluetooth 5.0, NFC, GPS, AGPS, LTE • Fingerabdrucksensor, Dual-SIM (Nano-SIM) • Betriebssystem: Android 12 Bestell-Nr.: 406 256 black 406 255 blue Smartphone • 16,72 cm (6,6“) Full HD+ Display • Octa-Core Prozessor (2 x 2,2 GHz + 6 x 1,8 GHz) • 4 GB Arbeitsspeicher, 64 GB interner Speicher, frei verfügbarer Speicher ca. 45,5 GB • Quad-Hauptkamera (50 Megapixel + 5 Megapixel + 2 Megapixel + 2 Megapixel), 8 Megapixel Frontkamera • WLAN, Bluetooth 5.1, NFC, GPS, 5G • Fingerabdrucksensor, Gesichtserkennung, Dual-SIM (Nano-SIM) • Betriebssystem: Android 12 Bestell-Nr.: 413 561 schwarz 413 562 weiß F mit 24 Monaten Elektro R. Meyer Garantie 279.Abhol-Barpreis 0% Ratenzahlung: 24 x 11,62 € monatlich = 279,- € Sonderposten begrenzte Stückzahl Abgabe nur in haushaltsüblichen Mengen 0% Zinsen F Ab 200,- € bis zu 24 Monate Laufzeit! Ohne Bank und ohne Bearbeitungsgebühr F 44cm(17,3‘‘) Intel® Core™ i5-1135G7 Prozessor 12 GB Arbeitsspeicher 512 GB SSD-Laufwerk mtl. 15.SUPER54 MONATE LEASINGVORTEILE INKL. REPARATUR + WARTUNG Vertragsentgelt 54 Monate x 15,00 € mtl. Leasinggebühr = 810,00 € (3 Monatsraten Kaution zu zahlen bei Vertragsbeginn) LEASING 149.Abhol-Barpreis mtl. 18.SUPER54 MONATE LEASINGVORTEILE INKL. REPARATUR + WARTUNG Vertragsentgelt 54 Monate x 18,00 € mtl. Leasinggebühr = 972,00 € (3 Monatsraten Kaution zu zahlen bei Vertragsbeginn) LEASING PC R5-5500 60 Years • AMD Ryzen™ 5 5500 Prozessor (bis zu 4,20 GHz, 16 MB Cache) • Asus TUF X570-Pro WiFi II Mainboard • 16 GB Arbeitsspeicher G-Skill DDR4-3200 RGB KIT • 1 x Samsung M2 500GB SSD 980 • 1 x Samsung M2 1TB SSD 980 • 8 GB Grafikkarte NVIDIA® GeForce® RTX3060Ti • be quiet Pure Power 11 750W Netzteil • Microsoft Windows® 11 Pro 64 Bit Bestell-Nr.: 415 467 Elektro R. Meyer Jubiläums-Edition mtl. 42.SUPER54 MONATE LEASINGVORTEILE INKL. REPARATUR + WARTUNG Vertragsentgelt 54 Monate x 42,00 € mtl. Leasinggebühr = 2268,00 € (3 Monatsraten Kaution zu zahlen bei Vertragsbeginn) LEASING Abhol-Barpreis 1999.= Hohe Leistung und Zuverlässigkeit! Sonderposten begrenzte Stückzahl Abgabe nur in haushaltsüblichen Mengen 34“ PREDATOR X34GSBMIIPPHUZX • 86,4 cm (34“) Diagonale, IPS-Panel, 21:9 Format • Auflösung: QHD 3440 x 1440 Pixel • Kontrastverhältnis: 1000:1 (statisch) • Reaktionszeit: 1 ms • Bildwiederholungsfrequenz: 180 Hz • Helligkeit: 400 cd/m² • 2x HDMI 2.0, 2x DP 1.4, 1x USB 3.0 Hub • G-Sync, neigbar, drehbar, höhenverstellbar Bestell-Nr.: 385 981 86,4cm (34‘‘) Abhol-Barpreis 899.mtl. SUPER54 MONATE LEASINGVORTEILE INKL. REPARATUR + WARTUNG Vertragsentgelt 54 Monate x 18,50 € mtl. Leasinggebühr = 999,00 € (3 Monatsraten Kaution zu zahlen bei Vertragsbeginn) LEASING 18.50 SuperLeasingknüller SuperLeasingknüller